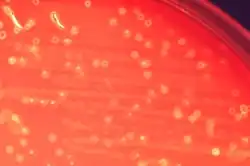

Streptococcus anginosus group
| Streptococcus milleri | |
|---|---|
| |
| Cultures of Streptococcus anginosus on blood agar | |
| Scientific classification | |
| Domain: | |
| Phylum: | |
| Class: | |
| Order: | |
| Family: | |
| Genus: | |
The Streptococcus anginosus group (SAG), also known as the anginosus group streptococci (AGS) or the milleri group streptococci (MGS), are a group of several species of streptococci with clinical similarities. The group is named after a principal member species, Streptococcus anginosus. The older name Streptococcus milleri (as well as Streptococcus milleri group, SMG) is now pseudotaxonomic, as the idea that these streptococci constituted a single species was incorrect. The anginosus group streptococci are members of the viridans streptococci group.[1] They have been implicated as etiologic agents in a variety of serious purulent infections, but because of their heterogeneous characteristics, these organisms may be unrecognized or misidentified by clinical laboratorians.[2] The unique characteristic of them from other pathogenic streptococci, such as S. pyogenes and S. agalactiae, is their ability to cause abscesses.[3][4]
Species
Members include:[2]
- Streptococcus anginosus
- Streptococcus constellatus
- S. constellatus subsp. constellatus
- S. constellatus subsp. pharyngis
- Streptococcus intermedius
Nomenclature
These nonhemolytic viridans streptococci were first described by Guthof in 1956 after he isolated them from dental abscesses. He named these organisms Streptococcus milleri in honor of the microbiologist W. D. Miller.[5][6]
Occurrence
The organisms were subsequently recognized as normal flora of the human oral cavity and gastrointestinal tract with the ability to cause abscesses and systemic infections.[7]
References
- ^ Streptococcus+milleri+group at the U.S. National Library of Medicine Medical Subject Headings (MeSH)
- ^ a b Ruoff, K L (Jan 1988). "Streptococcus anginosus ("Streptococcus milleri"): the unrecognized pathogen". Clinical Microbiology Reviews. 1 (1): 102–108. doi:10.1128/CMR.1.1.102. PMC 358032. PMID 3060239.
- ^ Gossling, J (Mar–Apr 1988). "Occurrence and pathogenicity of the Streptococcus milleri group". Reviews of Infectious Diseases. 10 (2): 257–85. doi:10.1093/clinids/10.2.257. PMID 3287560.
- ^ Rashid, R. M.; Salah, W.; Parada, J. P. (1 February 2007). "'Streptococcus milleri' aortic valve endocarditis and hepatic abscess". Journal of Medical Microbiology. 56 (2): 280–282. doi:10.1099/jmm.0.46781-0. PMID 17244814.
- ^ Whiley, RA; Beighton, D (January 1991). "Emended descriptions and recognition of Streptococcus constellatus, Streptococcus intermedius, and Streptococcus anginosus as distinct species". International Journal of Systematic Bacteriology. 41 (1): 1–5. doi:10.1099/00207713-41-1-1. PMID 1995029.
- ^ Verrall, R (November 1986). "The Streptococcus milleri group". Infection Control and Hospital Epidemiology. 7 (11): 558–60. doi:10.1017/S0195941700065334. JSTOR 30146431. PMID 3640746.
- ^ Mejàre, B; Edwardsson, S (November 1975). "Streptococcus milleri (Guthof); an indigenous organism of the human oral cavity". Archives of Oral Biology. 20 (11): 757–62. doi:10.1016/0003-9969(75)90048-5. PMID 1061530.
External links